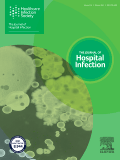
journal-of-hospital-infection

اخبار معاونت آموزش، تحقیقات و فناوری
گالری فیلم و عکس
اخبار پژوهشی مرکز
برگزاری کارگاه آموزشی تب دانگ
9 آبان 1403
برگزاری کارگاه آشنایی با سایت prospero
1 آبان 1403
برگزاری هشتمین جلسه شورای پژوهشی مرکز بیماری های عفونی گرمسیری
24 اردیبهشت 1403
برگزاری شورای پژوهشی بیماریهای عفونی گرمسیری
10 بهمن 1402
کارگاه دو روزه نگارش مقالات زیست پزشکی
13 دی 1402
جذب دکتری پژوهش محور
12 دی 1402
فرخوان جذب دستیار پژوهش
12 دی 1402
رویدادها
وبینار" مدیریت کووید در کودکان" برگزار شد.
25 مرداد 1401
نظرسنجی









































.png)
.png)
.png)
.png)
.png)

.png)